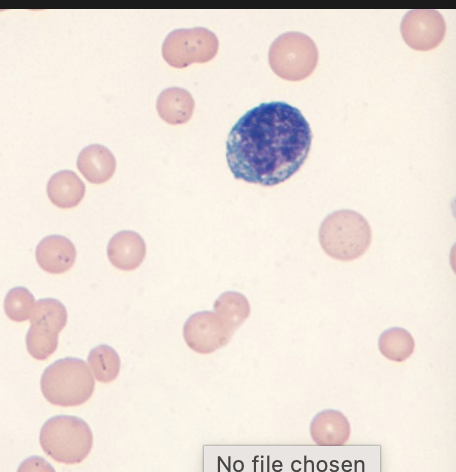
<p>Hemotropic mycoplasma in cats (mycoplasma hemofelis) </p>

Bacteria Presentations/ Disease Causing Bacteria
1/18
There's no tags or description
Looks like no tags are added yet.
Name | Mastery | Learn | Test | Matching | Spaced | Call with Kai |
|---|
No analytics yet
Send a link to your students to track their progress
19 Terms
Black Leg - Clostridium chauvei
Features: Often fatal disease, causes muscle necrosis, not zoonotic
Transmission: Ingested spores in soil
Bacterium: Anaerobic, gram positive bacterium that forms spores.
Prevention/Control: Vaccines, good colostrum, keep out of excavation areas/flooded pastures
Tx: Not usually successful- antibiotics IM, removal of damaged muscle
American Foulbrood (paenibacillus larvae)
Features: Highly contagious/fatal, affects honeybee larvae, no cure
Transmission: Bacterial Spores carried by worker bees, equipment,
Bacterium: Gram positive, facultative anaerobe rod-shaped bacterium that forms spores
Prevention/Control: Regular hive inspections, don’t get used equipment, can treat with Tylosin or Lincomycin
Mycoplasma Ovipneumoniae
Features: Affects sheep- wild and domestic - Multiple strains that affect different species. CS: Coughing, nasal discharge fever, inappetence
Transmission: Respiratory droplets/ nasal secretions, direct /close proximity
Bacterium: lacks cell wall= neither g - or g +
Prevention/Control: Preventing contact between wild/domestic sheep, no vaccine,
TX: broad spectrum antibiotics
Pasteurella Multocida- Fowl Cholera
Features: Affects poultry, CS: respiratory signs, fever, depression anorexia
high mortality, ZOONOTIC through bites/scratches
Transmission: Direct contact, contaminated water, fomites (humans, rodents, flies) migratory waterfowl are a natural reservoir
Bacterium: Gram negative coccobacillus
Prevention: Good biosecurity, rodent control, vaccination, housing birds indoors during peak migration seasons
Tx: Antibiotics- suppresses clinical signs - infections often return when treatment stops
Aeromonas salmonicida (Salmon Furunculosis)
Features: Affects majority of salmon, trout, charr
CS: tissue necrosis on dorsal muscles- boils on skin and muscle
Transmission: Direct contact, contaminated water, feces
Bacterium: gram negative, rod shaped
Prevention : Good water quality management, vaccination
Tx: Antibiotics through pellet feed SID for 10 days
What are the four bacteria pathogens to know for dogs
Kennel cough (bordetella bronchiseptica)
Leptospirosis
Lyme disease
Salmonella
3 important pathogenic bacteria to know in horses?
Strangles
Thrush
Tetanus
2 Common Bacteria pathogens in cats:
Mycoplasma species
hemotropic
Nonhemotropic
Chlamydia species
Bordetella bronchiseptica
Features: Cough/hacking
Bacterium: G neg coccobacilli
Tranmission: Nasal contact or aerosolized secretions
Prevention: Vaccine
Leptospirosis
Features: Acute kidney failure- elevated BUN and creatinine, decreased USG, liver enzymes elevated (ALP/ALT)
Bacterium: g neg spirochete
Transmission: contact with contaminated water
Prevention: vaccine, doxycycline
Diagnosis: PCR, SNAP, PCR
Lyme disease (Borrelia burgdorferi)
CS: lethargy, enlarged lymph nodes, fever, lameness
Bacterium: g neg spirochete- Zoonotic
Transmission: Ixodid tick bites- ,must be attached for over 24 hours
Prevention: vaccine or tick preventatives
TX: doxycycline
Diagnosis: PCR, C6 antibody test
Salmonella enterica
Bacterium: g neg bacillus (rod) facultative anaerobe Zoonotic
Transmission: Contaminated food/water- fecal oral route
Prevention: Educating reptile owners, bleach kennels, cooking food
Diagnosis: Difficult due to minimal clinical signs, culture the bacteria from the feces
Strangles- streptococcus equi
Features: Highly contagious, abscesses of mandibular and retropharyngeal lymph nodes- Purpura Hemorrhagica can develop after recovery from strangles
Bacterium: g positive, normal flora of horses but can lead to opportunistic infections
Transmission: infected horses, carrier horses, contaminated water troughs, stalls etc
CS: Fever, dysphagia, purulent nasal discharge, abscessed lymph nodes, guttural pouch disease
Prevention: Vaccine- not core, can cause purpura hemorrhagica
Diagnosis: C and S pus from the abscessed lymph node or PCR test
TX:
NSAID for pain and inflammation
lance abscesses and drain
Antibiotics controversial- reserved for severe cases
Quarantine
Thrush- fusobacterium necrophorum
Features: affects central and lateral sulci of frog
Bacterium: gram neg anaerobic bacteria
CS: Smelly hoof, black exudate in area of frog, lameness
Tx: remove necrotic tissue, epsom salt/ topical antiseptic iodine, copper sulfate bath, dry stall/ paddock
Prevention: Maintaining dry conditions, regular hoof care
Tetanus (Clostridium tetani)
Bacterium: Anaerobic gram pos spore forming rod
Transmission: wound on limb infected with bacterium from manure or soil
CS: Muscle spasms, lockjaw, stiff limbs, third eyelid prolapse
Diagnosis: Often done by clinical signs- other diagnostic tests are difficult to perform
TX: Antibiotics- metronidazole, sedation to help control muscle spasms, antitoxic
Prevention: Vaccination- core vaccine ( often in comno vaccines)
Mycoplasma in general
Bacterium: Acid fast gram neg facultative anaerobic gram neg (will not take up gram stain), difficult to culture
CS: URTI infections (upper resp) conjunctivitis or hemolytic anemia in cats, UTIs in dogs, respiratory infections, joint infections and mastitis in cattle
Diagnosis: ELISA or PCR
Hemotropic mycoplasma in cats (mycoplasma hemofelis)
Features: Feline infectious anemia, target RBCs (hemotropic)
Transmission: Cat fights, insect vectors
Diagnosis: Look for mycoplasma on RBCs (DONT USE EDTA LAVENDER TUBES) hard to find, may have to look several times
CS: male mm’s, lethargy, tachypnea if severe
TX: tetracyclines (doxycyclines)
Nonhemotropic Mycoplasmas in cats
Features: Upper respiratory tract infections, (along with other viral diseases like feline herpes virus, chlamydia, calicivirus)
CN: Conjunctivitis, UTIs, coughing, nasal discharge, sneezing
Diagnosis: PCR best, C and S difficult due to being normal flora of cats
TX: Tetracyclines: doxycycline,ophthalmological antibiotics may be required if ocular clinical signs
Chlamydia felis
Bacterium: gram neg obligate intracellular ( will not grown on standard culture media, requires animal cells to grow)
CS: Acute conjunctivitis, chemosis, nasal discharge, sneezing, fever, lethargy
Transmission: Ocular secretions and aerosolized methods
Diagnosis: Culture from conjunctival/nasal swabs
TX: systemic antibiotics- tetracyclines like doxycycline
Prevention:vaccines- vaccines for URT like feline herpes virus may also include chlamydia in the vaccine combo